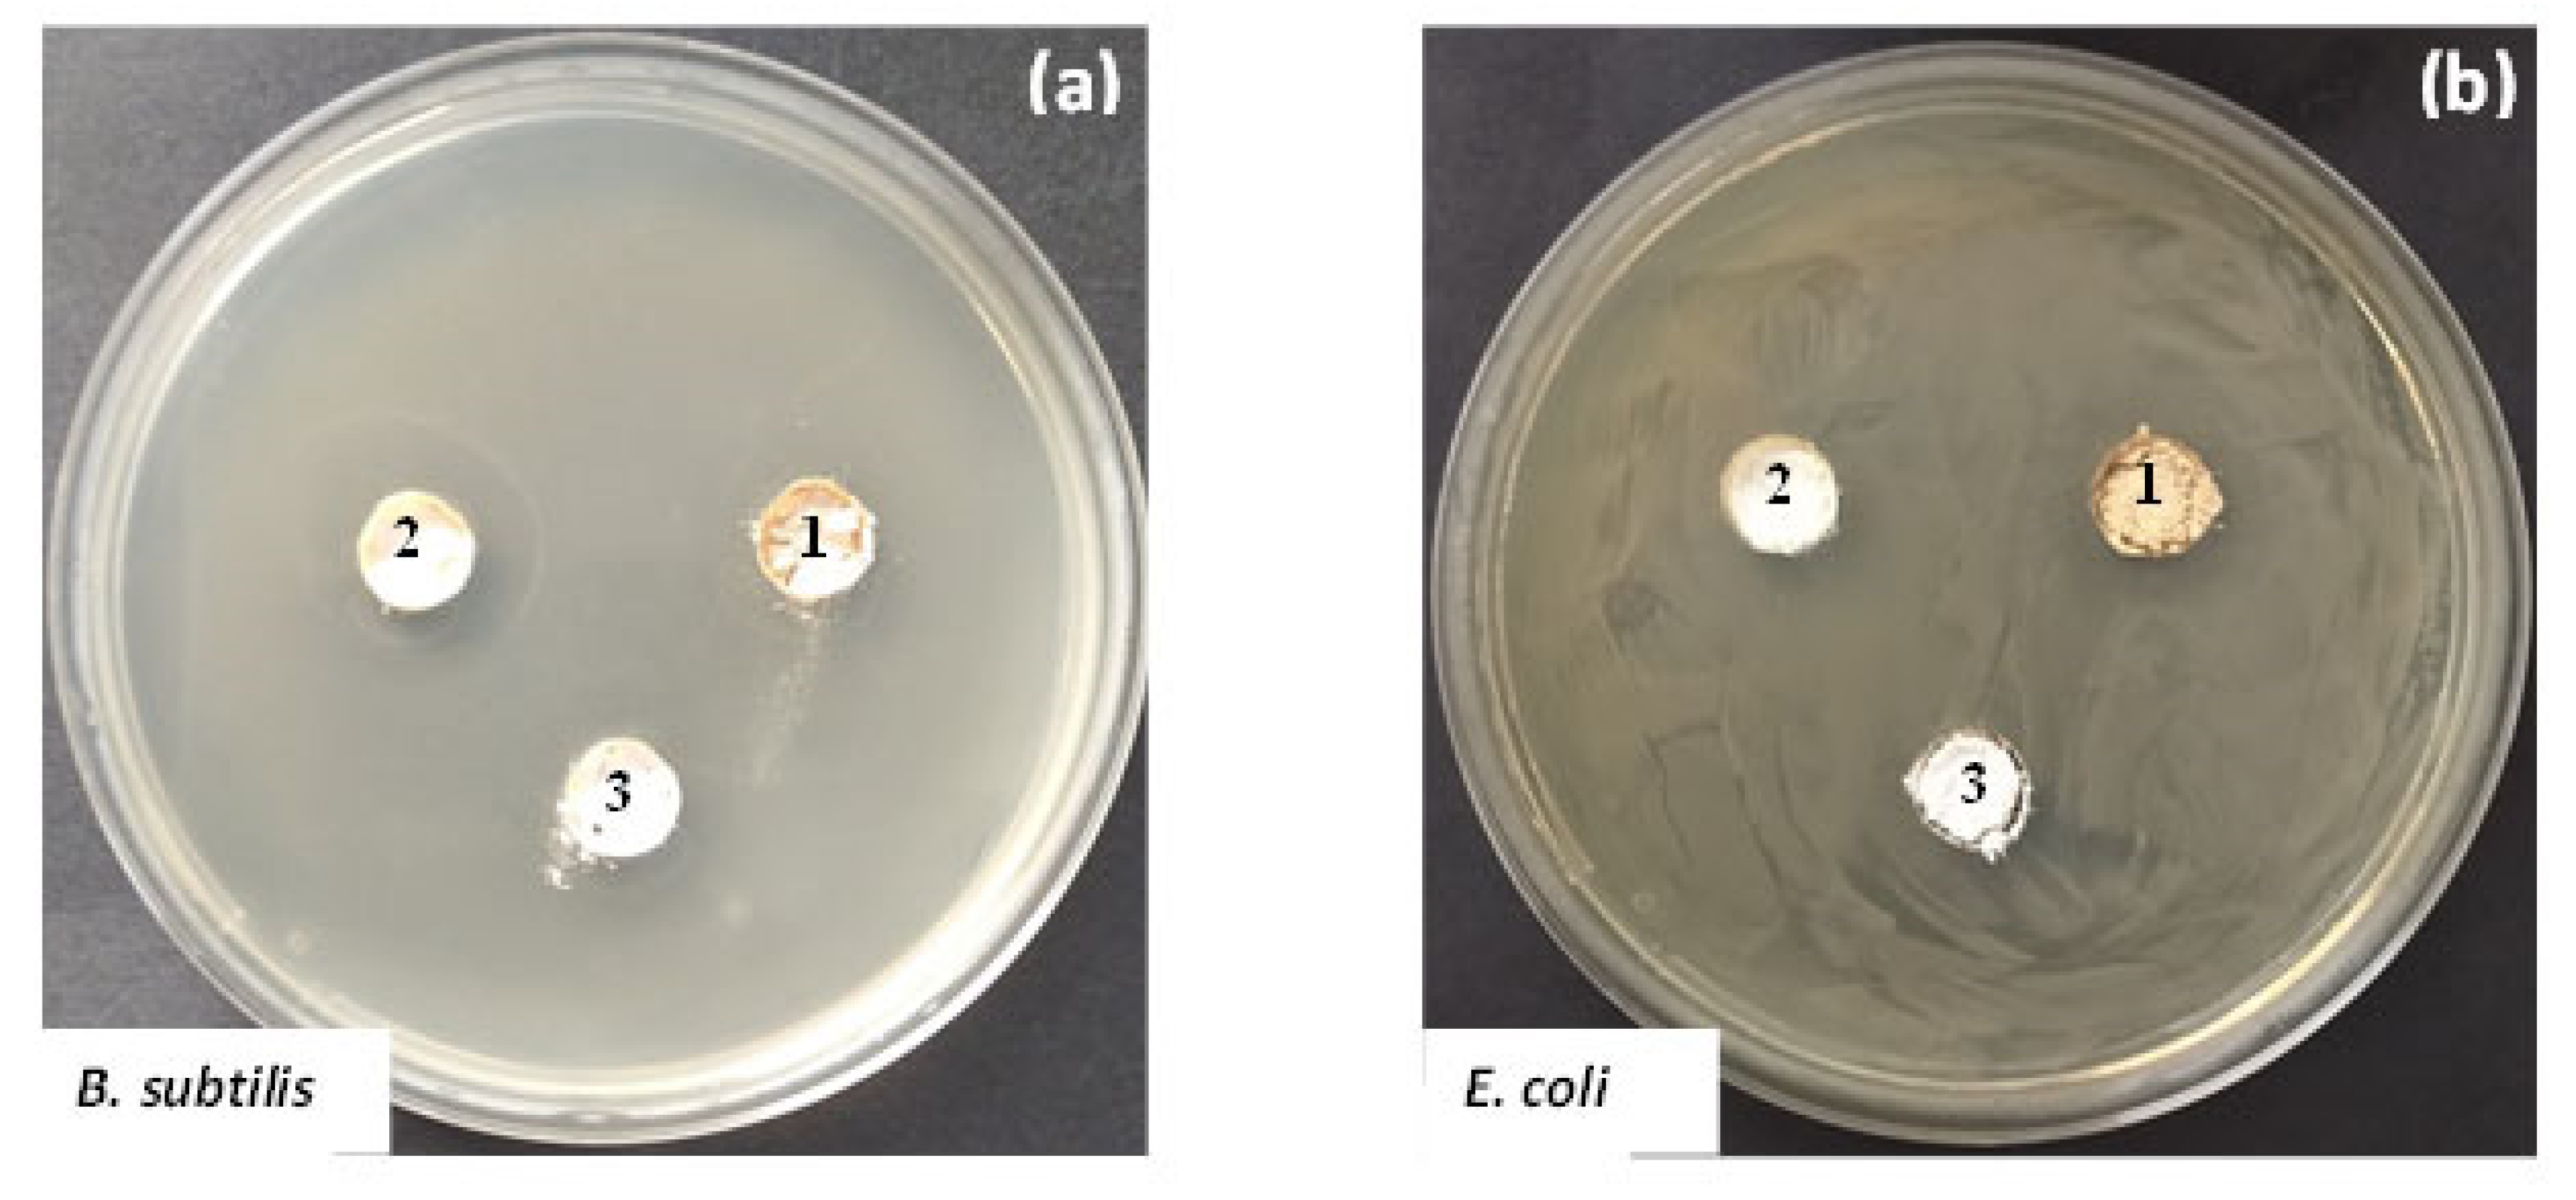
Molecules 26 03824 g010 550

The Influence of Nd and Sm on the Structure and Properties of Sol-Gel-Derived TiO2 Powders
Abstract
:1. Introduction
2. Results and Discussion
2.1. Phase Transformations
2.2. Thermal Stability of the Gels
2.3. Structural Studies and Optical Properties
UV-Vis Spectroscopy
2.4. Photocatalytic and Antibacterial Properties
2.4.1. Photocatalytic Activity
2.4.2. Antibacterial Activity
3. Materials and Methods
3.1. Materials and Reagents
3.2. Preparation of Nd and Sm-Modified TiO2 Gels
3.3. Characterization
3.4. Photocatalytic Experiments
3.5. Antibacterial Assay
3.5.1. Test Microorganisms, Media and Culture Conditions
3.5.2. Antimicrobial Activity Assay
4. Conclusions
Author Contributions
Funding
Institutional Review Board Statement
Informed Consent Statement
Data Availability Statement
Acknowledgments
Conflicts of Interest
Sample Availability
References
- Carp, O.; Huisman, C.L.; Reller, A. Photoinduced reactivity of titanium dioxide. Prog. Solid State Chem. 2004, 32, 33–177. [Google Scholar] [CrossRef]
- Gupta, S.M.; Tripathi, M. A review of TiO2 nanoparticles. Chin. Sci. Bull. 2011, 56, 1639–1657. [Google Scholar] [CrossRef] [Green Version]
- Zaleska, A. Doped-TiO2: A Review. Recent Pat. Eng. 2008, 2, 157–164. [Google Scholar] [CrossRef]
- Fagan, R.; McCormack, D.E.; Dionysiou, D.D.; Pillai, S.C. A Review of solar and visible light active TiO2 photocatalysts for treating bacteria, cyanotoxins and contaminants of emerging concern. Mater. Sci. Semicond. Proc. 2016, 42, 2–14. [Google Scholar] [CrossRef] [Green Version]
- Kumar, S.G.; Devi, L.G. Review on modified TiO2 photocatalysts under UV/Visible light: Selected results and related mechanisms on interfacial charge carrier transfer dynamics. J. Phys. Chem. A 2011, 115, 13211–13241. [Google Scholar] [CrossRef]
- Parnicka, P.; Mazierski, P.; Grzyb, T.; Lisowski, W.; Kowalska, E.; Ohtani, B.; Zaleska-Medynska, A.; Nadolna, J. Influence of the preparation method on the photocatalytic activity of Nd—Modified TiO2. Beilstein J. Nanotechnol. 2018, 9, 447–459. [Google Scholar] [CrossRef] [Green Version]
- Reszczyńska, J.; Grzyb, T.; Sobczak, J.W.; Lisowski, W.; Gazda, M.; Ohtani, B.; Zaleska, A. Visible light activity of rare earth metal doped (Er3+, Yb3+ or Er3+/Yb3+) titania photocatalysts. Appl. Catal. B Environ. 2015, 163, 40–49. [Google Scholar] [CrossRef]
- Sun, D.; Wang, K.; Xu, Z.; Li, R. Synthesis and photocatalytic activity of sulfate modified Nd-doped TiO2 under visible light irradiation. J. Rare Earths 2015, 33, 491–497. [Google Scholar] [CrossRef]
- Parnicka, P.; Mazierski, P.; Grzyb, T.; Wei, Z.; Kowalska, E.; Ohtani, B.; Klimczuk, T.; Nadolna, J. Preparation and photocatalytic activity of Nd-modified TiO2 photocatalysts: Insight into the excitation mechanism under visible light. J. Catal. 2017, 353, 211–222. [Google Scholar] [CrossRef]
- Zhang, H.; Sheng, Y.; Song, Y.; Li, H.; Huang, J.; Zheng, K.; Huo, Q.; Xu, X.; Zou, H. Uniform hollow TiO2:Sm3+ spheres: Solvothermal synthesis and luminescence properties. Powder Technol. 2013, 239, 403–408. [Google Scholar] [CrossRef]
- Cacciotti, I.; Bianco, A.; Pezzotti, G.; Gusmano, G. Synthesis, thermal behaviour and luminescence properties of rare earth-doped titania nanofibers. Chem. Eng. J. 2011, 166, 751–764. [Google Scholar] [CrossRef]
- Yuan, M.; Zhang, J.; Yan, S.; Luo, G.; Xu, Q.; Wang, X.; Li, C. Effect of Nd2O3 addition on the surface phase of TiO2 and photocatalytic activity studied by UV Raman spectroscopy. J. Alloys Compd. 2011, 509, 6227–6235. [Google Scholar] [CrossRef]
- Mazierski, P.; Lisowski, W.; Grzyb, T.; Winiarski, M.J.; Klimczuk, T.; Mikołajczyk, A.; Flisikowski, J.; Hirsch, A.; Kołakowska, A.; Puzyn, T.; et al. Enhanced photocatalytic properties of lanthanide-TiO2 nanotubes: An experimental and theoretical study. J. Appl. Catal. B Environ. 2017, 205, 376–385. [Google Scholar] [CrossRef]
- Qin, Y.; Hu, Z.; Lim, B.H.; Chang, W.S.; Chong, K.K.; Zhang, P.; Zhang, H. Sol-hydrothermal synthesis of TiO2:Sm3+ nanoparticles and their enhanced photovoltaic properties. J. Alloys Compd. 2016, 686, 803–809. [Google Scholar] [CrossRef]
- Reszczyńska, J.; Grzyb, T.; Wei, Z.; Klein, M.; Kowalska, E.; Ohtani, B.; Zaleska Medynska, A. Photocatalytic activity and luminescence properties of RE3+–TiO2 nanocrystals prepared by sol-gel and hydrothermal methods. Appl. Catal. B Environ. 2016, 181, 825–837. [Google Scholar] [CrossRef]
- Daghrir, R.; Drogui, P.; Robert, D. Modified TiO2 for Environmental Photocatalytic Applications: A Review. Ind. Eng. Chem. Res. 2013, 52, 3581–3599. [Google Scholar] [CrossRef]
- Stengl, V.; Bakardjieva, S.; Murafa, N. Preparation and photocatalytic activity of rare earth-doped TiO2 nanoparticles. Mater. Chem. Phys. 2009, 114, 217–226. [Google Scholar] [CrossRef]
- Dinkar, A.V.; Shridhar, J.S.; Madhukar, E.N.; Anil, A.; Nitin, K. Sm-Doped TiO2 Nanoparticles with High Photocatalytic Activity For ARS Dye Under Visible Light Synthesized by Ultrasonic Assisted Sol-Gel Method. Orient. J. Chem. 2016, 32, 933–940. [Google Scholar] [CrossRef] [Green Version]
- Kiisk, V.; Reedo, V.; Sild, O.; Sildos, I. Luminescense properties of sol-gel derived TiO2: Sm powder. Opt. Mater. 2009, 31, 1376–1379. [Google Scholar] [CrossRef]
- Xiao, Q.; Si, Z.; Yu, Z.; Qiu, G. Characterization and photocatalytic activity of Sm3+-doped TiO2 nanocrystalline prepared by low temperature combustion method. J. Alloys Compd. 2008, 450, 426–431. [Google Scholar] [CrossRef]
- Xu, A.-W.; Gao, Y.; Liu, H.-Q. The Preparation, Characterization, and their Photocatalytic Activities of Rare-Earth-Doped TiO2 Nanoparticles. J. Catal. 2002, 207, 151–157. [Google Scholar] [CrossRef]
- Khade, G.V.; Suwarnkar, M.B.; Gavade, N.L.; Garadkar, K.M. Sol-gel microwave assisted synthesis of Sm-doped TiO2 nanoparticles and their photocatalytic activity for the degradation of Methyl Orange under sunlight. J. Mater. Sci. Mater. Electr. 2016, 27, 6425–6432. [Google Scholar] [CrossRef]
- Chen, R.; Song, W. Facile synthesis and enhanced photocatalysis of Sm doped TiO2. Adv. Mater. Res. 2012, 490–495, 3272–3276. [Google Scholar]
- Arasi, S.E.; Madhavan, J.; Ray, M.V.J. Effect of samarium (Sm3+) doping on structural, optical properties and photocatalytic activity of titanium dioxide nanoparticles. J. Taibah Univ. Sci. 2018, 12, 186–190. [Google Scholar] [CrossRef] [Green Version]
- Bokare, A.; Sanap, A.; Pai, M.; Sabharwal, S.; Athawale, A.A. Antibacterial activities of Nd doped and Ag coated TiO2 nanoparticles under solar light irradiation. Colloids Surf. B Biointerfaces 2013, 102, 273–280. [Google Scholar] [CrossRef]
- Xu, M.; Da, P.; Wu, H.; Zhao, D.; Zheng, G. Controlled Sn-Doping in TiO2 nanowire photoanodes with enhanced photoelectrochemical conversion. Nano Lett. 2012, 12, 1503–1508. [Google Scholar] [CrossRef]
- Jaiswal, S.; McHale, P.; Duffy, B. Preparation and rapid analysis of antibacterial silver, copper and zinc doped sol-gel surfaces. Colloid Surf. B 2012, 94, 170–176. [Google Scholar] [CrossRef] [Green Version]
- Luu, C.L.; Nguyen, Q.T.; Ho, S.T. Synthesis and characterization of Fe-doped TiO2 photocatalyst by the sol–gel method. Adv. Nat. Sci. Nanosci. Nanotechnol. 2010, 1, 015008-13. [Google Scholar] [CrossRef]
- Bachvarova-Nedelcheva, A.; Iordanova, R.; Stoyanova, A.; Gegova, R.; Dimitriev, Y.; Loukanov, A. Photocatalytic properties of ZnO/TiO2 powders obtained via combustion gel method. Cent. Eur. J. Chem. 2013, 11, 364. [Google Scholar] [CrossRef] [Green Version]
- Shalaby, A.; Angelova, T.; Bachvarova-Nedelcheva, A.; Georgieva, N.; Iordanova, R.; Staneva, A.; Dimitriev, Y. Sol-gel synthesis of materials in the system SiO2/ZnO/TiO2/RGO and their antimicrobial efficiency against E. coli K12. C. R. Acad. Bulg. Sci. 2016, 69, 25–30. [Google Scholar]
- Bachvarova-Nedelcheva, A.; Iordanova, R.; Gegova, R.; Dimitriev, Y. Sol–gel synthesis, characterization and optical properties of TiO2/TeO2 powders, Bulg. Chem. Commun. 2016, 48, 5–10. [Google Scholar]
- Stoyanova, A.; Hitkova, H.; Ivanova, N.; Bachvarova-Nedelcheva, A.; Iordanova, R.; Sredkova, M. Photocatalytic and antibacterial activity of Fe-doped TiO2 nanoparticles prepared by nonhydrolytic sol-gel method, Bulg. Chem. Commun. 2013, 45, 497–504. [Google Scholar]
- Bachvarova-Nedelcheva, A.; Iordanova, R.; Stoyanova, A.; Georgieva, N.; Angelova, T. Sol-gel synthesis of Se and Te containing TiO2 nanocomposites with photocatalytic and antibacterial properties. J. Optoel. Adv. Mater. 2016, 18, 5–9. [Google Scholar]
- Stoyanova, A.M.; Koleva, T.K.; Bachvarova-Nedelcheva, A.D.; Iordanova, R.S. Photocatalytic Bleaching of Two Organic Dyes Catalyzed by La-Doped Nanosized TiO2. Bulg. Chem. Commun. 2015, 47, 118–124. [Google Scholar]
- Stoyanova, A.; Bachvarova-Nedelcheva, A.; Iordanova, R. Photocatalytic degradation of two azo-dyes in single and binary mixture by La modified TiO2. J. Chem. Technol. Metall. 2018, 53, 1173–1178. [Google Scholar]
- Stoyanova, A.; Ivanova, N.; Bachvarova-Nedelcheva, A.; Christov, C. Synthesis and photocatalytic activity of cerium-doped and cerium-boron co-doped TiO2 nanoparticles. J. Chem. Technol. Metall. 2021, in press. [Google Scholar]
- Bingham, S.; Daoud, W.A. Recent advances in making nano-sized TiO2 visible-light active through rare-earth metal doping. J. Mater. Chem. 2011, 21, 2041–2050. [Google Scholar] [CrossRef]
- Saquib, N.; Adnan, R.; Shah, I. A mini-review on rare earth metal-doped TiO2 for photocatalytic remediation of wastewater. Environ. Sci. Pollut. Res. 2016, 23, 1594–1595. [Google Scholar] [CrossRef]
- Yadav, S.; Jaiswar, G. Review on Undoped/Doped TiO2 Nanomaterial; Synthesis and Photocatalytic and Antimicrobial Activity. J. Chin. Chem. Soc. 2016, 64, 103–116. [Google Scholar] [CrossRef]
- Du, J.; Chen, H.; Yang, H.; Sang, R.; Qian, Y.; Li, Y.; Zhu, G.; Mao, Y.; He, W.; Kang, D.J. A facile sol-gel method for synthesis of porous Nd-doped TiO2 monolith with enhanced photocatalytic activity under UV–Vis irradiation. Microporous Mesoporous Mater. 2013, 182, 87–94. [Google Scholar] [CrossRef]
- Nassoko, D.; Li, Y.-F.; Li, J.-L.; Li, X.; Lu, Y. Neodymium-Doped with Anatase and Brookite Two Phases: Mechanism for Photocatalytic Activity Enhancement under Visible Light and the Role of ElectronInternational. J. Photoenergy 2012, 2012, 716087. [Google Scholar] [CrossRef] [Green Version]
- Bachvarova-Nedelcheva, A.; Yordanov, S.; Iordanova, R.; Stambolova, I. Comparative study of sol–gel derived pure and Nd-doped TiO2 nanopowders. J. Chem. Technol. Metall. 2018, 53, 1167–1172. [Google Scholar]
- Yordanov, S.; Bachvarova-Nedelcheva, A.; Iordanova, R.; Stambolova, I. Sol-gel synthesis and properties of Sm modified TiO2 nanopowders. Bulg. Chem. Commun. 2018, 50, 42–48. [Google Scholar]
- Yordanov, S.; Bachvarova-Nedelcheva, A.; Iordanova, R. Influence of ethylene glycol on the hydrolysis-condensation behavior of Ti(IV) butoxide. Bulg. Chem. Commun. 2017, 49, 265–270. [Google Scholar]
- Niu, W.; Bi, X.; Wang, G.; Sun, X. TiO2 Gel Thin Film Doped Ce and Sm Preparation and Cyclic Voltammetry Characteristics. Int. J. Electrochem. Sci. 2013, 8, 11943–11950. [Google Scholar]
- Huang, F.P. Preparation and photocatalytic property of Nd doped TiO2 photocatalyst. In Proceedings of the International conference on Manipulation, Manifacturing and Measurment on the Nanoscale (3M-NANO), Xi’an, China, 29 August–1 September 2012; pp. 97–101. [Google Scholar]
- Bachvarova-Nedelcheva, A.; Yordanov, S.; Iordanova, R.; Stambolova, I. The solvent role on the hydrolysis-condensation processes and obtaining of TiO2 nanopowders. J. Chem. Technol. Metall. 2019, 54, 292–302. [Google Scholar]
- Siwinska-Stefanska, K.; Zdarta, J.; Paukszta, D.; Jesionowski, T. The influence of addition of a catalyst and chelating agent on the properties of titanium dioxide synthesized via the sol-gel method. J. Sol-Gel Sci. Technol. 2015, 75, 264–278. [Google Scholar] [CrossRef] [Green Version]
- Gao, X.; Wachs, I.E. Titania-silica as catalysts: Molecular structural characteristics and physico-chemical properties. Catal. Today 1999, 51, 233–254. [Google Scholar] [CrossRef]
- Sanchez, J.C.; Henry, M.L.; Babonneau, F. Chemical modification of alkoxide precursor. J. Non Cryst. Sol. 1988, 100, 65–76. [Google Scholar] [CrossRef]
- Leustic, A.; Babonneau, F.; Livage, J. Structural investigations of the hydrolysis-condensation process ot titanium alkoxides Ti(OR)4 (OR = OPri, OEt) modified by AcAc, 2. From the modified precursor to the colloids. Chem. Mater. 1989, 1, 248–252. [Google Scholar] [CrossRef]
- Barlier, V.; Bounor-Legare, V.; Boiteux, G.; Davenas, J. Hydrolysis–condensation reactions of titanium alkoxides in thin films: A study of the steric hindrance effect by X-ray photoelectron spectroscopy. Appl. Surf. Sci. 2008, 254, 5408–5412. [Google Scholar] [CrossRef]
- Gegova, R.; Bachvarova-Nedelcheva, A.; Iordanova, R.; Dimitriev, Y. Synthesis and crystallization of gels in the TiO2-TeO2-ZnO system. Bulg. Chem. Commun. 2015, 47, 378–386. [Google Scholar]
- Gegova, R.; Iordanova, R.; Bachvarova-Nedelcheva, A.; Dimitriev, Y. Synthesis, structure and properties of TiO2-TeO2-MnOm (M = Zn, B) gels: A comparison. J. Chem. Technol. Metall. 2015, 50, 449–458. [Google Scholar]
- Wang, C.; Xu, B.-Q.; Wang, X.; Zhao, J. Preparation and photocatalytic activity of ZnO/TiO2/SnO2 mixture. J. Solid State Chem. 2005, 178, 3500–3506. [Google Scholar] [CrossRef]
- Samadi, S.; Yousefi, M.; Khalilian, F.; Tabatabaee, A. Synthesis, characterization, and application of Nd, Zr–TiO2/SiO2 nanocomposite thin films as visible light active photocatalyst. J. Nanostruct. Chem. 2015, 5, 7–15. [Google Scholar] [CrossRef] [Green Version]
- Iordanova, R.; Gegova, R.; Bachvarova-Nedelcheva, A.; Dimitriev, Y. Sol-gel synthesis of composites in the ternary TiO2-TeO2-B2O3 system. Phys. Chem. Glasses Eur. J. Glass Sci. Technol. B 2015, 56, 128–138. [Google Scholar] [CrossRef]
- Antoinette, M.M.; Israel, S. Synthesis and Characterization of Sm2O3 Nanoparticles using combustion method. Intern. Res. J. Eng. Technol. 2017, 4, 276–279. [Google Scholar]
- Gupta, S.K.; Ghosh, P.S.; Pathak, N.; Arya, A.; Natarajan, V. Understanding the local environment of Sm3+ in doped SrZrO3 and energy transfer mechanism using time resolved luminescence: A combined theoretical and experimental approach. RCS Adv. 2021, in press. [Google Scholar] [CrossRef]
- Choudhury, B.; Borah, B.; Choudhury, A. Ce–Nd codoping effect on the structural and optical properties of TiO2 nanoparticles. Mater. Sci. Eng. B 2013, 178, 239–247. [Google Scholar] [CrossRef]
- Wang, C.; Ao, Y.; Wang, P.; Hou, J.; Qian, J. Preparation, characterization and photocatalytic activity of the neodymium-doped TiO2 hollow spheres. Appl. Surf. Sci. 2010, 257, 227–231. [Google Scholar] [CrossRef]
- Khodadadi, B. Effects of Ag, Nd codoping on structural, optical and photocatalytic properties of TiO2 nanocomposite synthesized via sol-gel method using starch as a green additive. Iran. J. Catal. 2016, 6, 305–311. [Google Scholar]
- Beydoun, D.; Amal, R.; Low, G.; McEvoy, S. Role of Nanoparticles in Photocatalysis. J. Nanopart. Res. 1999, 1, 439–458. [Google Scholar] [CrossRef]
- Nahar, M.S.; Hasegawa, K.; Kagaya, S. Photocatalytic degradation of phenol by visible light-responsive iron-doped TiO2 and spontaneous sedimentation of the TiO2 particles. Chemosphere 2006, 65, 1976–1982. [Google Scholar] [CrossRef]
- Qian, R.; Zong, H.; Schneider, J.; Zhou, G.; Zhao, T.; Li, Y.; Yang, J.; Bahnemann, D.; Pan, J.H. Charge carrier trapping, recombination and transfer during TiO2 photocatalysis: An overview. Catal. Today 2019, 335, 78–90. [Google Scholar] [CrossRef]
- Blaskov, V.; Ninova, I.; Znaidi, L.; Stambolova, I.; Michel, J.P.; Vassilev, S.; Beauverger, M.; Klissurski, D.; Kanaev, A. SEM characterization of spin-coated nanocrystalline TiO2 thin film influenced by the presence of acetylacetone during the sol preparation. In Nanoscience & Nanotechnology, 4th ed.; Balabanova, E., Dragieva, I., Eds.; Heron Press: Sofia, Bulgaria, 2004; Volume 4, pp. 191–193. [Google Scholar]
- Sannino, F.; Pernice, P.; Imparato, C.; Aronne, A. Hybrid TiO2-Acetylacetonate Amorphous Gel-Derived Material with Stably Adsorbed Superoxide Radical Active in Oxidative Degradation of Organic Pollutants. RSC Adv. 2015, 5, 93831–93839. [Google Scholar] [CrossRef]
- Valgas, C.; de Souza, S.M.; Smania, E.F.A., Jr. Screening methods to determine antibacterial activity of natural products. Braz. J. Microbiol. 2007, 38, 369–380. [Google Scholar] [CrossRef] [Green Version]

| Gels Composition, mol % | UV-Vis Results | |
|---|---|---|
| Eg, eV | Cut-Off, nm | |
| TiO2 (Ti(IV) isopropoxide) | 3.37 | 367.69 |
| TS (2% Sm) | 2.90 | 431.98 |
| TN (2% Nd) | 2.61 | 474.24 |
Publisher’s Note: MDPI stays neutral with regard to jurisdictional claims in published maps and institutional affiliations. |
© 2021 by the authors. Licensee MDPI, Basel, Switzerland. This article is an open access article distributed under the terms and conditions of the Creative Commons Attribution (CC BY) license (https://creativecommons.org/licenses/by/4.0/).
Share and Cite
Bachvarova-Nedelcheva, A.; Yordanov, S.; Iordanova, R.; Stambolova, I.; Stoyanova, A.; Georgieva, N.; Nemska, V. The Influence of Nd and Sm on the Structure and Properties of Sol-Gel-Derived TiO2 Powders. Molecules 2021, 26, 3824. https://doi.org/10.3390/molecules26133824
Bachvarova-Nedelcheva A, Yordanov S, Iordanova R, Stambolova I, Stoyanova A, Georgieva N, Nemska V. The Influence of Nd and Sm on the Structure and Properties of Sol-Gel-Derived TiO2 Powders. Molecules. 2021; 26(13):3824. https://doi.org/10.3390/molecules26133824
Chicago/Turabian StyleBachvarova-Nedelcheva, Albena, Stancho Yordanov, Reni Iordanova, Irina Stambolova, Angelina Stoyanova, Nelly Georgieva, and Veronica Nemska. 2021. "The Influence of Nd and Sm on the Structure and Properties of Sol-Gel-Derived TiO2 Powders" Molecules 26, no. 13: 3824. https://doi.org/10.3390/molecules26133824
APA StyleBachvarova-Nedelcheva, A., Yordanov, S., Iordanova, R., Stambolova, I., Stoyanova, A., Georgieva, N., & Nemska, V. (2021). The Influence of Nd and Sm on the Structure and Properties of Sol-Gel-Derived TiO2 Powders. Molecules, 26(13), 3824. https://doi.org/10.3390/molecules26133824








